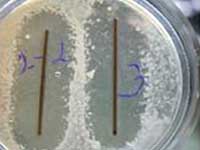

Серія: «Фізика радіаційних ушкоджень та радіаційне матеріалознавство»
Ознайомитися із опублікованими працями можна за цим посиланням.
Докладено результати дослідження залежності адсорбції різних іонів на поверхні діоксиду титану від pH середовища та рівняння, що описують цю залежність.